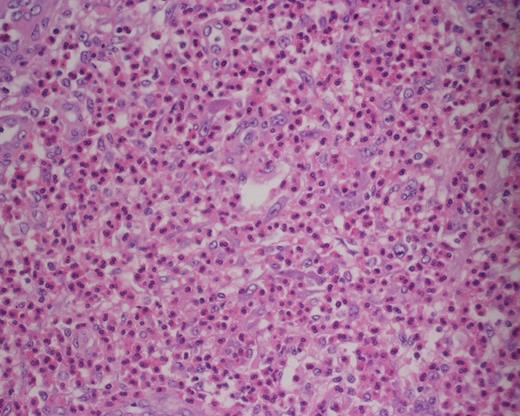
Photomicrograph of haematoxylin and eosin (H&E)-stained sections (×400) showing collection of eosinophils within the paracortex.

-
PDF
- Split View
-
Views
-
Cite
Cite
Alexander M. Bobinskas, Arun Chandu, Alf L. Nastri, Kimura's disease: an uncommon cause of head and neck masses with potentially serious sequelae, Journal of Surgical Case Reports, Volume 2015, Issue 10, October 2015, rjv131, https://doi.org/10.1093/jscr/rjv131
Close - Share Icon Share
Abstract
Kimura's disease (KD) typically presents as a mass in the head and neck region in association with eosinophilia and elevated serum IgE. Excisional biopsy is often required in order to obtain an adequate sample for histological diagnosis and exclude malignancy. If suspected, patients should also be investigated for renal involvement as this may complicate KD. Treatment options include surgical excision and medical therapies such as corticosteroids depending on the extent and severity of disease.
INTRODUCTION
Kimura's disease (KD) is an uncommon, benign, chronic inflammatory disorder of unknown aetiology [1]. KD typically presents as a painless subcutaneous swelling in the preauricular and submandibular regions, though involvement of the orbit, eyelids, epiglottis, axilla, forearm, groin or popliteal region has been reported [2].
CASE REPORT
A 52-year-old female of Chinese decent was referred regarding a persistent right submandibular swelling thought to be related to an odontogenic infection.
History revealed 2 months of progressive painless right submandibular swelling despite several courses of oral antibiotics and recent dental extraction. She denied any infective or respiratory symptoms, weight loss or dysphagia. Aside from right submandibular chronic sclerosing sialadenitis treated via surgical excision, the patient had no medical history, no known allergies and took no regular medications.
Clinical examination revealed a firm, non-tender, swelling of the right submandibular region with no overlying skin changes. No trismus or intraoral abnormality was noted. Laboratory investigations were unremarkable other than an increased eosinophil count of 1.8 × 109/l (normal range 0.0–0.5 × 109/l) and serum creatinine of 91 µmol/l (normal range 49–90 µmol/l).
Computed tomography (CT) identified several enlarged submandibular lymph nodes (Figs 1 and 2).

Axial CT neck (post contrast) showing enlarged right submandibular nodes.

Coronal CT (post contrast) showing enlarged right submandibular nodes.
Fine needle aspiration (FNA) biopsy of a right submandibular lesion was non-diagnostic; however, subsequent excisional biopsy indicated KD.
The patient was referred to rheumatology and commenced on cetrizine and a tapering course of oral prednisolone. By 3 months, the submandibular swelling had clinically resolved, and at 9 months, the patient remained recurrence free with normal renal function and eosinophil count. Shortly after cessation of prednisolone, submandibular swelling and eosinophilia recurred; therefore, oral steroids were recommenced.
DISCUSSION
KD most commonly, though not exclusively, occurs in young and middle-aged adults of Asian descent affecting men more commonly than women [3].
Although the aetiology of KD remains uncertain, the general consensus is that KD is a chronic inflammatory condition [4]. Alternative proposed aetiologies include neoplasia, parasitic infection, atopic reaction or immune response to various pathogens, in particular, candida albicans [4]; however, no causative agent has been isolated in lesions of KD [5]. No malignant change has been reported [3].
Differential diagnoses of KD include tuberculosis, nodal metastases, lymphoma, eosinophilic granuloma, granulomatous diseases, salivary gland pathologies, lymphadenitis, drug reaction and angiolymphoid hyperplasia with eosinophilia (ALHE) [1, 4, 6]. The most controversial of these is ALHE, as at times ALHE and KD have been considered to be the same disease. Recent literature, however, describes these as two distinct entities [4].
Laboratory investigations typically reveal eosinophilia and elevated serum IgE levels. The degree of eosinophilia may correlate with the size of lesions [7], and recurrences may be more likely in patients with eosinophil counts >50% and serum IgE >10 000 IU/ml [8].
Magnetic resonance imaging and CT assist in assessing lesions and their relations to surrounding structures, with lesions often being ill defined and of variable appearance on cross-sectional imaging [2]. Lesions have been found to be diffusely avid on positron emission tomography scanning and may resemble neoplastic disorders [9]. Given the non-specific radiological findings, imaging alone is often insufficient to exclude malignancy; thus, diagnosis is based on biopsy in conjunction with clinical features and laboratory findings [3]. Once the diagnosis of KD has been established, further imaging to assess for distant lesions is not considered essential.
Histologically, KD demonstrates follicular hyperplasia with reactive germinal centres, and there is often IgE deposition and eosinophilic infiltration of germinal centres and interfollicular zones. Lysis of follicles with microabscess formation may also be present [10] (Figs 3 and 4). FNA is generally inadequate to diagnose KD; consequently, open biopsy is often required to provide diagnostic tissue samples [11].
Photomicrograph of haematoxylin and eosin (H&E)-stained sections (×400) showing collection of eosinophils within the paracortex.

Photomicrograph of H&E-stained sections (×200) showing microabscess formation.
Management options include observation, medical therapies, surgical excision and radiotherapy. Observation may be acceptable if lesions are asymptomatic and not cosmetically concerning; however, untreated lesions tend to slowly enlarge and may become disfiguring [11]. Reported medical treatments include corticosteroids, cetrizine, trans-retinoic acid, pentoxifyline, cyclosporine, oxyphenbutazone, vincristine and pranlukast [1, 3].
Excisional biopsy has been advocated as the initial treatment of choice as it provides tissue for histological diagnosis and may be curative [4]. Recurrence has been reported in up to 25% of patients treated with surgical excision alone [1]. In cases of initial recurrence, where feasible, re-excision is an option [4]. Iwai et al. reported that recurrences occurred between 1.3 and 2.5 years in patients treated with surgery [8], whilst Zhang et al. found recurrences developed between 15 and 20 months in patients treated with radiotherapy [12]. Given these reports, it would appear prudent to keep patients under review for at least 3 years following the completion of treatment to monitor for recurrence. Given that KD is a non-malignant disease, radiotherapy is generally limited to cases not amenable to surgery or those who have failed medical therapies [4].
Nephrotic syndrome and renal impairment are important sequelae of KD, which may affect up to 60% of patients [6]. Patients with renal complications should be referred to a renal physician. In patients with severe renal disease, aggressive treatment with corticosteroids, cyclophosphamide and antiplatelet drugs has been recommended [5].
In summary, all patients presenting with a progressive head and neck swelling should be thoroughly investigated to exclude malignancy. Although KD is an uncommon disease, medical and dental practitioners should be aware of the condition because of its ability to become disfiguring, recur and result in renal complications. The presence of eosinophilia and elevated serum IgE should suggest the possibility of KD and if suspected patients should be investigated for renal involvement and referred accordingly.
CONFLICT OF INTEREST STATEMENT
None declared.